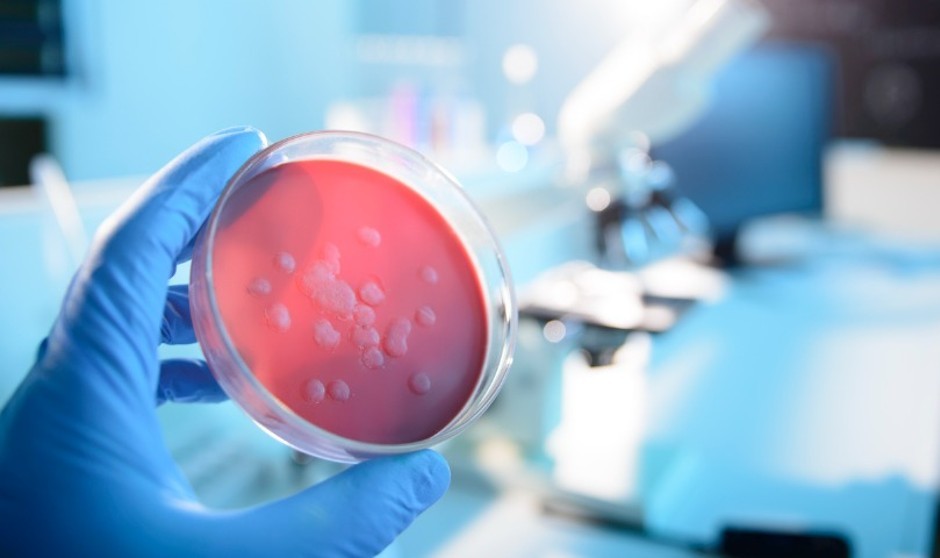

Imagen de archivo de un laboratorio farmacéutico.
La resistencia a los antibióticos es hoy una de las mayores amenazas para la salud mundial, la seguridad alimentaria y el desarrollo del planeta. Puede comprometer muchos avances médicos que dependen de los antibióticos, como la cirugía, la quimioterapia o el tratamiento de enfermedades crónicas.
Según el Centro Europeo para la Prevención y Control de Enfermedades (ECDC), las infecciones causadas por bacterias resistentes a los antibióticos provocan la muerte de más de 30.000 europeos al año, una cifra que se eleva a 700.000 personas en ámbito mundial. Además, la Organización Mundial de la Salud (OMS) advirtió hace unos años de que para 2050 en el mundo habrá más muertes relacionadas con superbacterias resistentes que por cáncer, incluso que será la principal causa de muerte en el planeta.
Ante este panorama, científicos, profesionales sanitarios, autoridades competentes en medicamentos e industria farmacéutica coinciden en que hay que actuar en dos ámbitos. El primero, utilizar menos y mejor los antibióticos que ya se comercializan, y el segundo, hacer mucho más atractiva la investigación de nuevos antibióticos. Es decir, hoy sólo existe un camino para combatir la resistencia a los antimicrobianos (RAM): nuevos antibióticos eficaces y uso responsable de los existentes.
La pandemia por la Covid-19 ha mostrado que el liderazgo de la industria farmacéutica ha sido imprescindible para proporcionar a la sociedad las vacunas que han permitido afrontar la crisis. Sin embargo, los costes y el alto riesgo que implica la I+D de nuevos medicamentos chocan en el caso de los nuevos antibióticos con la necesidad por parte de las autoridades sanitarias de limitar al máximo su uso, reservándolos para los casos más complicados. Se compromete así la principal vía de retorno económico para las compañías desarrolladoras, con lo que es obligado buscar nuevas fórmulas que incentiven la investigación en este terreno.
Ante el creciente reto que está suponiendo la RAM y la dificultad de abordar la I+D en este campo, las instituciones europeas y la industria farmacéutica innovadora están trabajando para encontrar soluciones. En esta línea, una nueva investigación realizada por la consultora Charles Rives Associates, publicada este miércoles por la Federación Europea de la Industria Farmacéutica (Efpia), podría allanar el camino para encontrar una solución permanente para incentivar la investigación y el desarrollo de nuevos antibióticos en la UE. En concreto, analiza la fórmula de la Extensión de la Exclusividad Transferible (EET), que es un incentivo gracias al cual la compañía biofarmacéutica que investiga y desarrolla un nuevo antimicrobiano recibe un cupón o autorización para extender la exclusividad de comercialización de uno de sus productos en otras áreas.
Cabe recordar que todos los medicamentos nuevos gozan de un periodo de exclusividad para que su comercialización pueda optar al retorno de lo invertido en investigación. Pasado el periodo de exclusividad, el precio del tratamiento sufre una rebaja por la entrada de competidores (genéricos o biosimilares). La EET plantea que una empresa que lograra llevar al mercado un antimicrobiano considerado de interés fuera recompensada mediante un derecho transferible para extender el período de exclusividad de otro producto. Esta fórmula podría aplicarse por la misma compañía que desarrolló el nuevo antimicrobiano dentro de su propia cartera o ser vendido a otra empresa.
El análisis de costes y beneficios de la medida realizado por Charles River Associates demuestra los beneficios potenciales (clínicos y económicos) y disipa los temores de que la medida resulte costosa para los Estados miembro. De hecho, el estudio muestra que generaría cientos de millones de euros de ahorro para los países de manera individual y proporciona una solución sostenible a largo plazo para revitalizar la cartera de antibióticos.
Uno de los países analizados por el informe es España, para el que estima beneficios clínicos por valor de hasta 25 millones de euros, 23 millones en productividad y hasta 327 millones por trasmisiones evitadas en la próxima década.
Más ventajas que inconvenientes
Entre las ventajas de la EET, los autores del informe destacan que puede implementarse a través de legislación de la UE; no requiere financiación anticipada de los gobiernos y es independiente de la situación económica y los cambios políticos en los Estados miembro; abordaría el fracaso del marco actual de incentivos al ofrecer un incentivo a la altura del reto que supone la I+D de antimicrobianos y reconocer el valor que estos productos aportan a la sociedad; apoyaría a todas las compañías farmacéuticas con independencia de su tamaño, pues serían premiadas tan pronto como el nuevo antimicrobiano recibiese aprobación regulatoria, y respeta un uso prudente de los antibióticos al desvincular la recompensa económica del número de recetas.
Como demuestra este estudio, la industria farmacéutica innovadora está firmemente comprometida en la búsqueda de soluciones que permitan, entre todos los agentes implicados, afrontar el problema a través de la investigación, desarrollo y uso adecuado de nuevos y más eficaces medicamentos antimicrobianos, que deben complementarse con otras medidas como la reducción de las infecciones a través de la higiene y la prevención, el uso adecuado de los actuales antibióticos, el fomento de la vacunación o el control de la liberación de antibióticos al medio ambiente que se produce, entre otros factores, a través de la alimentación del ganado.
“El reto fundamental consiste, pues, en superar la citada paradoja de que, por razones sanitarias, cada nuevo antibiótico va a ser escasamente utilizado, y por eso se deben buscar nuevos modelos económicos que permitan generar incentivos financieros sostenibles para los laboratorios que están trabajando en el desarrollo de estos medicamentos”, afirma Emili Esteve, director del Departamento Técnico de Farmaindustria.
“Esta iniciativa demuestra el compromiso de los laboratorios innovadores con el desafío de impulsar la investigación en áreas no rentables. Debemos dar con soluciones modernas e imaginativas que, también con la colaboración de las instituciones públicas, nos permitan avanzar en este camino”, concluye Esteve.
Mientras, las compañías farmacéuticas siguen implicadas en la investigación de nuevos medicamentos contra las infecciones. Cerca de 90 medicamentos están en desarrollo para combatir las infecciones resistentes a los tratamientos actuales. Estos potenciales fármacos están dirigidos a combatir 17 patógenos distintos y la utilidad de muchos de ellos se está estudiando en varios de estos patógenos a la vez.
 REGÍSTRATE GRATIS
REGÍSTRATE GRATIS
PARA SEGUIR LEYENDO
 ¿Ya eres premium? Inicia sesión
¿Ya eres premium? Inicia sesión

Aviso importante
El usuario desde el que está intentando acceder a este contenido no está registrado como profesional autorizado para acceder a esta información. Esta noticia informa sobre novedades farmacológicas y, por ley, está reservada a profesionales de la salud habilitados para la prescripción o dispensación de medicamentos.
Volver a la portada de Redacción Médica
Las informaciones publicadas en Redacción Médica contienen afirmaciones, datos y declaraciones procedentes de instituciones oficiales y profesionales sanitarios. No obstante, ante cualquier duda relacionada con su salud, consulte con su especialista sanitario correspondiente.